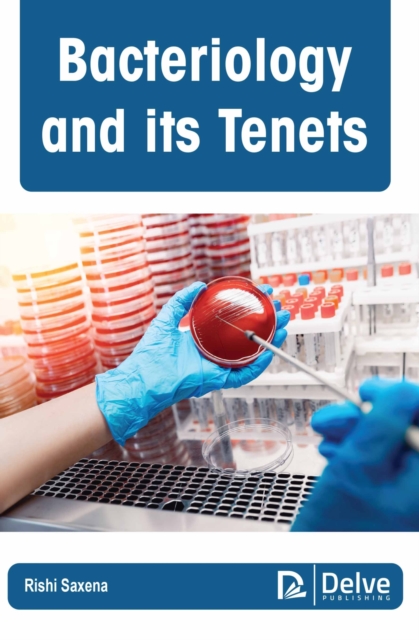
Bacteriology and Its Tenets

Bacteriology and Its Tenets
Autor: Saxena, Rishi
Disponibilitate: LIVRARE IN 4-6 saptamani (produsul este livrat din Marea Britanie)
SKU:
9781774695043
1009.99 RON
Okian.ro este o LIBRARIE online de carte in limba engleza.
DETALII
Citeste mai mult
Descriere RO
AutorSaxena, Rishi
EdituraArcler Press
Dimensiuni229 x 152
Data Publicarii01/12/2022
FormatCartonata
Numar pagini240